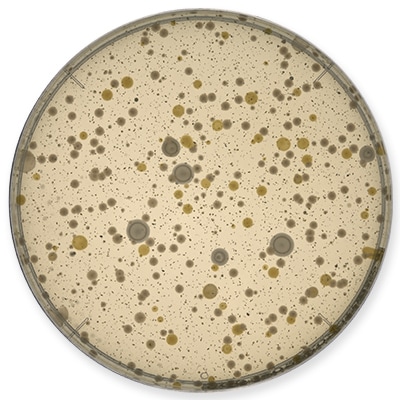

微生物検査(細菌検査)での菌数測定(コロニーカウント)の手法
微生物検査(細菌検査)の主な目的
微生物検査(細菌検査)の目的は、食品や化粧品などの製品の衛生面・安全面などに関わる検査と、感染症に関わる医療的な検査に大別されます。
ここでは、直接体に摂取する食品の微生物検査(細菌検査)や人体に直接使用する化粧品・医薬部外品(薬用化粧品)といった製品の微生物試験とそれらの目的について解説します。
食品の微生物検査(細菌検査)の目的と実施の流れ
食品の微生物検査(細菌検査)とは、食品事業者が食品の安全性管理を目的に、食中毒を引き起こす微生物(細菌)の有無や衛生状態を確認するために菌数を調べることです。
微生物(細菌)の検査は、基準や規格(日本では食品衛生法や食品衛生規範)で定められており、食品事業者は、これに準じた検査を行うことにより、原材料の調達・製造・輸送・保管といったフードチェーン全体で食品の安全性を確保・確認する必要があります。
食品検査の中でも、食品製造時の微生物検査(細菌検査)では、食品が微生物(細菌)に関する成分規格に適合しているかどうかを調べます。これは衛生管理の指標である一般生菌数や大腸菌群、食中毒の原因となる微生物(細菌)などを検出し、食品が規格基準に適合しているかどうかを確認して食品衛生を確保するための重要な検査です。
また、製品の出荷後に消費者からクレームがあった場合や、製造した食品が原因と推定される食中毒の発生時には、その原因を究明するために、残った食品や材料の成分分析や、製造に用いた調理器具・機器、施設内の拭き取り検査などによる工場環境の微生物検査がなど行われ、再発防止策を検討、実施します。
食品の微生物検査(細菌検査)は以下のような流れで行われます。
(1)試料を調製する
微生物(細菌)を正確に検出するため無菌環境で行います。生菌数・大腸菌群・黄色ブドウ球菌などを調べる検査では蒸留水に塩類などを加えた希釈水、腸管出血性大腸菌・サルモネラ・腸炎ビブリオなどの食中毒菌を調べる検査では蒸留水に微生物(細菌)が増殖しやすい栄養分を加えた増菌培地を用います。
多くの場合は食品を25g(あるいは食品によって一定量)取り、測り取った食品の9倍量の希釈水を加えて試料原液を作成し、それをストマッカーと呼ばれる装置を用いて全体を均一にします。
(2)試料を検出培地に接種・培養する
均一にした試料原液を段階的に希釈し(10倍~1万倍程度)、それぞれ検出培地に加えるまたは塗り広げるなどして、一定時間・至適温度(調べる微生物や細菌によって培養条件が異なるが多くの場合、48時間)で培養します。
検査対象の微生物(細菌)をより多く培養して検出しやすくするために、検査する微生物(細菌)の種類ごとに異なる検出培地(寒天または液体)を用います。
使用する検出培地の例として、一般生菌数では標準寒天培地、大腸菌群・大腸菌(E.coli)ではデソキシコレート寒天培地、EMB培地やXMG寒天培地、黄色ブドウ球菌では卵黄加マンニット食塩寒天培地やベアードパーカー寒天培地、腸管出血性大腸菌ではCT-ソルビトールマッコンキー(CT-SMAC)寒天培地などが挙げられます。
(3)培養結果の判定
培地上に出現したコロニー数を計測し、計測結果を基準値と照らし合わせて合否の判定をおこないます。
化粧品・医薬部外品の微生物検査(細菌検査)とその目的
日本では、化粧品や医薬部外品(薬用化粧品)の製造と使用時の安全性確保を目的に、国際標準規格ISO17516(Microbiological Limits)に準拠する日本化粧品工業連合会の自主基準として微生物の検査(微生物試験)が規定されています。
このうち微生物限度試験では、各条件で微生物試験を実施し、微生物(細菌)の数が定められた限度値(微生物限度値)を超えていないか確認します。生菌数の限度値の規定では、大腸菌や緑膿菌、黄色ブドウ球菌などの特定微生物数が、陰性または規定の限度値未満である必要があります。
また、保存剤(防腐剤・殺菌剤など)の添加による効果を評価する保存効力試験では、試験菌(特定微生物)を接種・配合し、経時的にそれらの消長を追跡します。製品製造(未使用)時の基準適合に加え、使用時に混入した微生物(細菌)が減少する、または増加限度の基準に適合する必要があり、適切な防腐力設計が求められます。
検査対象となる主な微生物(細菌)
食品の微生物検査(細菌検査)においては、その食品の微生物汚染の判断材料の一つとして衛生指標菌が用いられます。代表的な衛生指標菌としては、一般生菌、大腸菌群、大腸菌、黄色ブドウ球菌などが挙げられます。これらは食中毒菌と密接な関係にあり、衛生指標菌を検査することで食品の安全性を確認しています。
一般生菌
一般的に、標準寒天培地を用いて好気的条件下で、35℃±1.0℃で48時間±3時間培養(食品によっては24時間±2時間の場合もある)したときにコロニー(集落)を形成する細菌を言い、最近の種類を特定するものではありません。その為食中毒をおこす汚染と直接関係があるわけではありませんが、一般生菌には無害な細菌だけでなく病原性大腸菌など食中毒につながる細菌も含まれるため、一般生菌数が多いと食中毒のリスクも高くなると言えます。
大腸菌群

好気性もしくは通性嫌気性のグラム陰性無芽胞桿菌で、乳糖を分解して酸とガスを産生する細菌です。大腸菌群には大腸菌以外の属(クレブエシラ属、エンテロバクター属など)も含まれ、ヒトや動物の糞便だけでなく、土壌、水など自然界に広く分布しています。大腸菌群は過熱に弱いため、加熱済み食材から検収される場合は、加熱不足や二次汚染が疑われます。器具の拭き取り検査や、未加熱食品等で多く検出される場合は、器具の洗浄殺菌不良や手洗いの不足など、非衛生的な取り扱いを受けたことを示します。
大腸菌: E.coli(Escherichia coli)
大腸菌はヒトや動物の糞便に存在しますが、自然界では死滅しやすいため、大腸菌が検出された場合は直接的または間接的に、且つ比較的新しい時期に糞便汚染があったことを意味し、サルモネラ菌や腸管出血性大腸菌など感染型病原菌の存在を示唆しています。食品衛生法においては、食肉製品、生食用食肉、生食用かきおよび凍結前未加熱・加熱後接種冷凍食品について規格基準が設けられています。
特定病原菌
日本化粧品工業会連合会により自主基準としてまとめられた「化粧品の製造及び品質管理に関する技術指針」の中で規定されているもので、大腸菌群(主としてE.coli)、緑膿菌、黄色ブドウ球菌、サルモネラの4種をさし、化粧品から検出されてはいけないとされる病原微生物です。
その他の微生物
乳酸菌

私たちの食文化にとって身近な微生物として知られる乳酸菌。意図的に転嫁することで、チーズやヨーグルトなどの様々な発酵食品を作ることができます。日本では、厚生労働省の「乳及び乳製品の成分規格等に関する省令(乳等省令)」によって発酵乳と乳製品乳酸菌飲料の成分規格が定められ、同じく乳等省令によって定められた方法で検査されます。
健康に良い乳酸菌ですが、意図せずに食品に混入した場合にはパッケージの膨張や、異臭(エタノール臭)や異味の発生、酸敗や緑変、粘着化などを引き起こす可能性もあります。しかし現状、発酵乳と乳製品乳酸菌飲料以外の食品には乳酸菌に関する明確な成分規格を定めた法令等はなく、各社の自主基準により検査が行われています。
微生物検査(細菌検査)におけるカウント方法
微生物(細菌)は非常に小さいため、そのままでは肉眼で観察することができず、菌数を数えることもできません。微生物の数を調べるには大きく二つの方法があります。一つは、顕微鏡で直接観察して数える方法です。ほとんどの微生物(細菌)はそのままの状態では無色透明のため、グラム染色により可視化したり、微分干渉顕微鏡や位相差顕微鏡を用いてコントラストを付けた像を観察したりすることが一般的です。この方法により得られた数を総菌数と言います。
もう一つの方法は、培養することで形成される集落(コロニー)を数える方法です。この方法で数えた菌数はCFU(Colony Forming Unit、集落形成単位)という単位であらわされます。コロニーのカウントは従来から目視でおこなわれており、拡大用のルーペやバックライト照明が内蔵された手動式コロニーカウンターなどカウントを補助する機器もありますが、結局は検査担当者の熟練度や作業スピードに依存せざるをえず、その効率化が長年の課題となっていました。
自動コロニーカウンターを活用した微生物検査(細菌検査)・微生物試験の課題解決
手動式コロニーカウンターなどを用いた従来の目視カウントでは、検査担当者の熟練度により作業スピードに大きな差が生じるほか、複数の担当者で検査を実施している場合はその熟練度などによりカウント結果にバラつきが生じたり、単独であっても体調などの要因で同じカウント結果が得られなかったりするなど、安定した結果を得ることが困難であるといった問題もありました。
キーエンスの高精度自動コロニーカウンタBC-1000は、デジタルマイクロスコープ等で培った高度なレンズ・照明光学技術と高画素CMOSカメラでシャーレの画像を撮影し、独自のカウント専用アルゴリズムを搭載した画像処理を施すことで、わずか1秒でコロニー数のカウントが可能。目視によるカウントに比べて作業時間を圧倒的に短縮できます。また、常に同じ条件でのカウントが可能なため、バラつきのない安定したカウントが可能です。担当者の熟練度に依存しないため、急な人員交代や、事業拡大などにより検査品目、点数が増えた場合の人員補充などへの対応も容易になります。


- 高精度自動コロニーカウンタ BC-1000を導入すれば
-
- デジタルマイクロスコープなどの高精度な光学顕微鏡の開発で培った光学技術によりどんなサンプルも鮮明に映し出し、独自アルゴリズム搭載の画像処理技術により素早く正確なカウント結果が得られます。
- ボタンを押してから最短1秒でカウント。検査にかかる作業工数を劇的に短縮できます。
- 熟練度による結果のばらつきが生じないため、検査担当者が変わったり人員を増やしたりしても、同じ基準で安定した結果を得ることができます。

